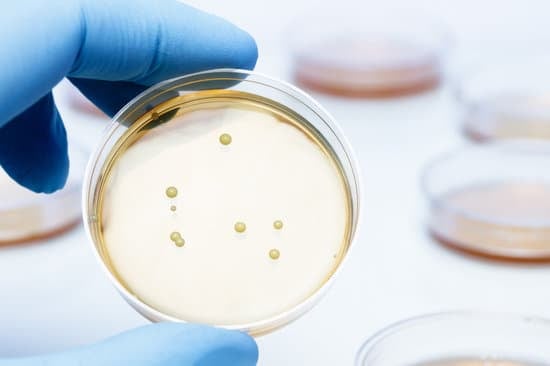

락토바실러스(Lactobacillus)에 대한 이해
락토바실러스(Lactobacillus)는 유산균의 한 종류로, 장내 미생물의 균형을 유지하고 소화 건강과 면역력을 강화하는 데 중요한 역할을 합니다.
이 유익한 세균은 주로 발효 식품(예: 요구르트, 김치, 치즈)에서 발견되며, 프로바이오틱스 보충제의 주요 성분으로도 사용됩니다.
주요 효능
장 건강 개선:
락토바실러스는 장내 유익균을 증가시키고, 유해균을 억제하여 장내 균형을 유지합니다. 이로 인해 소화불량, 변비, 설사 등의 증상이 완화될 수 있습니다.
면역력 강화:
락토바실러스는 면역 체계를 활성화시켜 감염 예방에 도움을 줍니다. 특히, 장벽을 강화하여 유해물질의 침입을 막고, 면역세포의 기능을 개선합니다.
질 건강 유지:
여성의 질 내 환경을 유지하는 데 중요한 역할을 하며, 질염과 같은 질환 예방에 도움을 줄 수 있습니다. Lactobacillus rhamnosus와 Lactobacillus reuteri는 특히 여성 건강에 유익합니다.
정신 건강 지원:
최근 연구에 따르면, 락토바실러스는 장-뇌 축을 통해 스트레스 감소와 불안증 완화에 긍정적인 영향을 미칠 수 있습니다. 장내 미생물이 정신 건강과 밀접한 관련이 있다는 연구 결과들이 증가하고 있습니다.
주요 종
Lactobacillus acidophilus: 가장 흔히 사용되는 유산균으로, 장 건강과 면역력 강화에 효과적입니다.
Lactobacillus rhamnosus: 여성의 질 건강과 감염 예방에 도움을 줍니다.
Lactobacillus casei: 소화 기능 개선과 면역력 강화에 도움을 주는 유익균입니다.
섭취 방법
발효식품: 락토바실러스는 요구르트, 김치, 치즈 등의 발효식품에서 자연적으로 섭취할 수 있습니다.
프로바이오틱스 보충제: 다양한 락토바실러스 균주가 포함된 보충제를 통해 섭취할 수 있습니다.
일반적으로 하루에 수십억 CFU(CFU, colony-forming units)를 권장합니다.
자주 묻는 질문 (FAQ)
Q1: 락토바실러스는 모든 사람에게 효과가 있나요?
답변: 대부분의 사람들에게 락토바실러스는 안전하고 효과적입니다. 그러나 특정 알레르기나 면역 체계 문제로 인해 섭취에 주의가 필요한 경우도 있습니다. 따라서 보충제를 섭취하기 전에 전문가와 상담하는 것이 좋습니다.
Q2: 락토바실러스 보충제를 언제 섭취하는 것이 가장 효과적인가요?
답변: 일반적으로 공복 상태에서 섭취하는 것이 좋습니다. 아침에 기상 후 또는 잠들기 전이 권장됩니다.
Q3: 얼마나 자주 섭취해야 하나요?
답변: 락토바실러스는 매일 꾸준히 섭취하는 것이 좋습니다. 장기적인 효과를 위해서는 지속적인 섭취가 필요합니다.
락토바실러스는 장 건강을 비롯해 면역력, 질 건강, 그리고 정신 건강까지 다양한 영역에서 유익한 효과를 제공하는 중요한 유산균입니다.
개인의 건강 상태에 따라 맞춤형 섭취가 필요할 수 있습니다.
여성 유산균 선택하는 방법
여성 유산균 선택하는 방법여성 유산균은 여성의 장 건강뿐만 아니라 질 건강, 면역력 증진 등 다양한 이점을 제공하는 보충제입니다.올바른 유산균을 선택하기 위해서는 몇 가지 중요한 요소
namo4.namo38.com
'건강상식' 카테고리의 다른 글
| 고주파 치료(Radiofrequency Ablation, RFA)의 원리와 적응증 (0) | 2024.08.21 |
|---|---|
| 목의 통증을 줄이는 운동 방법 (0) | 2024.08.21 |
| 여성 유산균 선택하는 방법 (0) | 2024.08.20 |
| 보스웰리아(Boswellia)의 효능과 섭취방법 (0) | 2024.08.19 |
| 이노시톨(Inositol)의 형태와 효능 (0) | 2024.08.19 |